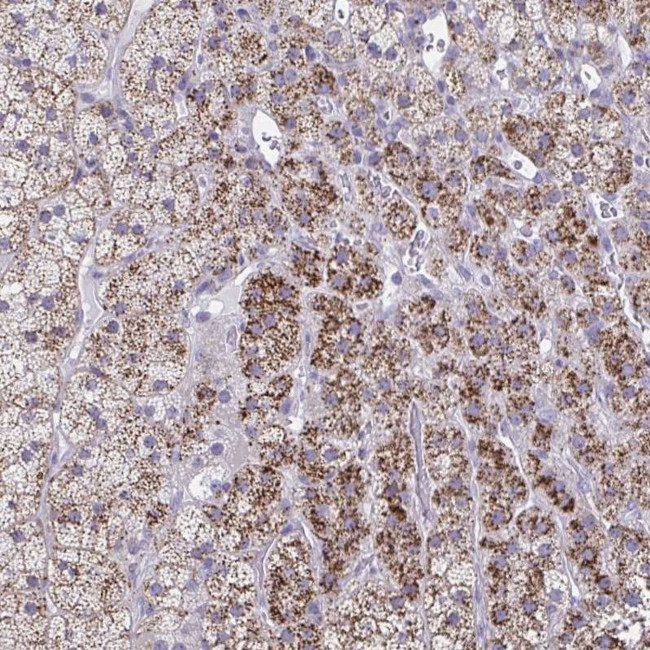
LRRC4B Antibody in Immunohistochemistry (Paraffin) (IHC (P))

Search
Invitrogen
LRRC4B Polyclonal Antibody
{{$productOrderCtrl.translations['antibody.pdp.commerceCard.promotion.promotions']}}
{{$productOrderCtrl.translations['antibody.pdp.commerceCard.promotion.viewpromo']}}
{{$productOrderCtrl.translations['antibody.pdp.commerceCard.promotion.promocode']}}: {{promo.promoCode}} {{promo.promoTitle}} {{promo.promoDescription}}. {{$productOrderCtrl.translations['antibody.pdp.commerceCard.promotion.learnmore']}}
产品信息
PA5-63638
种属反应
宿主/亚型
分类
类型
抗原
偶联物
形式
浓度
规格
纯化类型
保存液
内含物
保存条件
运输条件
RRID
产品详细信息
Immunogen sequence: GTEKEPPGPT TDGVWGGGRP GDAAGPASSS TTAPAPRSSR PTEKAFTVPI TDVTENALKD LDD
Highest antigen sequence identity to the following orthologs: Mouse - 94%, Rat - 94%.
靶标信息
The LRRC4B gene encodes a protein known as leucine-rich repeat-containing protein 4B, which is involved in cellular signaling and neural development. LRRC4B is a member of the leucine-rich repeat (LRR) protein family, characterized by its ability to mediate protein-protein interactions through its LRR domains. This protein is predominantly expressed in the nervous system and plays a crucial role in neuronal growth, synapse formation, and signal transduction pathways essential for brain development and function. LRRC4B contributes to cell adhesion, growth cone guidance, and synaptic plasticity, influencing the formation and maintenance of neural circuits. Its dysregulation has been linked to neurodevelopmental disorders, highlighting its importance in cognitive functions and neurological health. Additionally, LRRC4B is implicated in cancer biology, where it may act as a tumor suppressor, modulating cellular proliferation and migration. Research continues to explore LRRC4B's interactions and regulatory mechanisms, offering insights into potential therapeutic applications for neurological diseases and cancer.
仅用于科研。不用于诊断过程。未经明确授权不得转售。
篇参考文献 (0)
生物信息学
蛋白别名: Leucine-rich repeat-containing protein 4B; leucine-rich repeats and immunoglobulin-like domains 4; netrin-G ligand-3; Netrin-G3 ligand; NGL-3
基因别名: HSM; LRIG4; LRRC4B; NGL-3
UniProt ID: (Human) Q9NT99
Entrez Gene ID: (Human) 94030